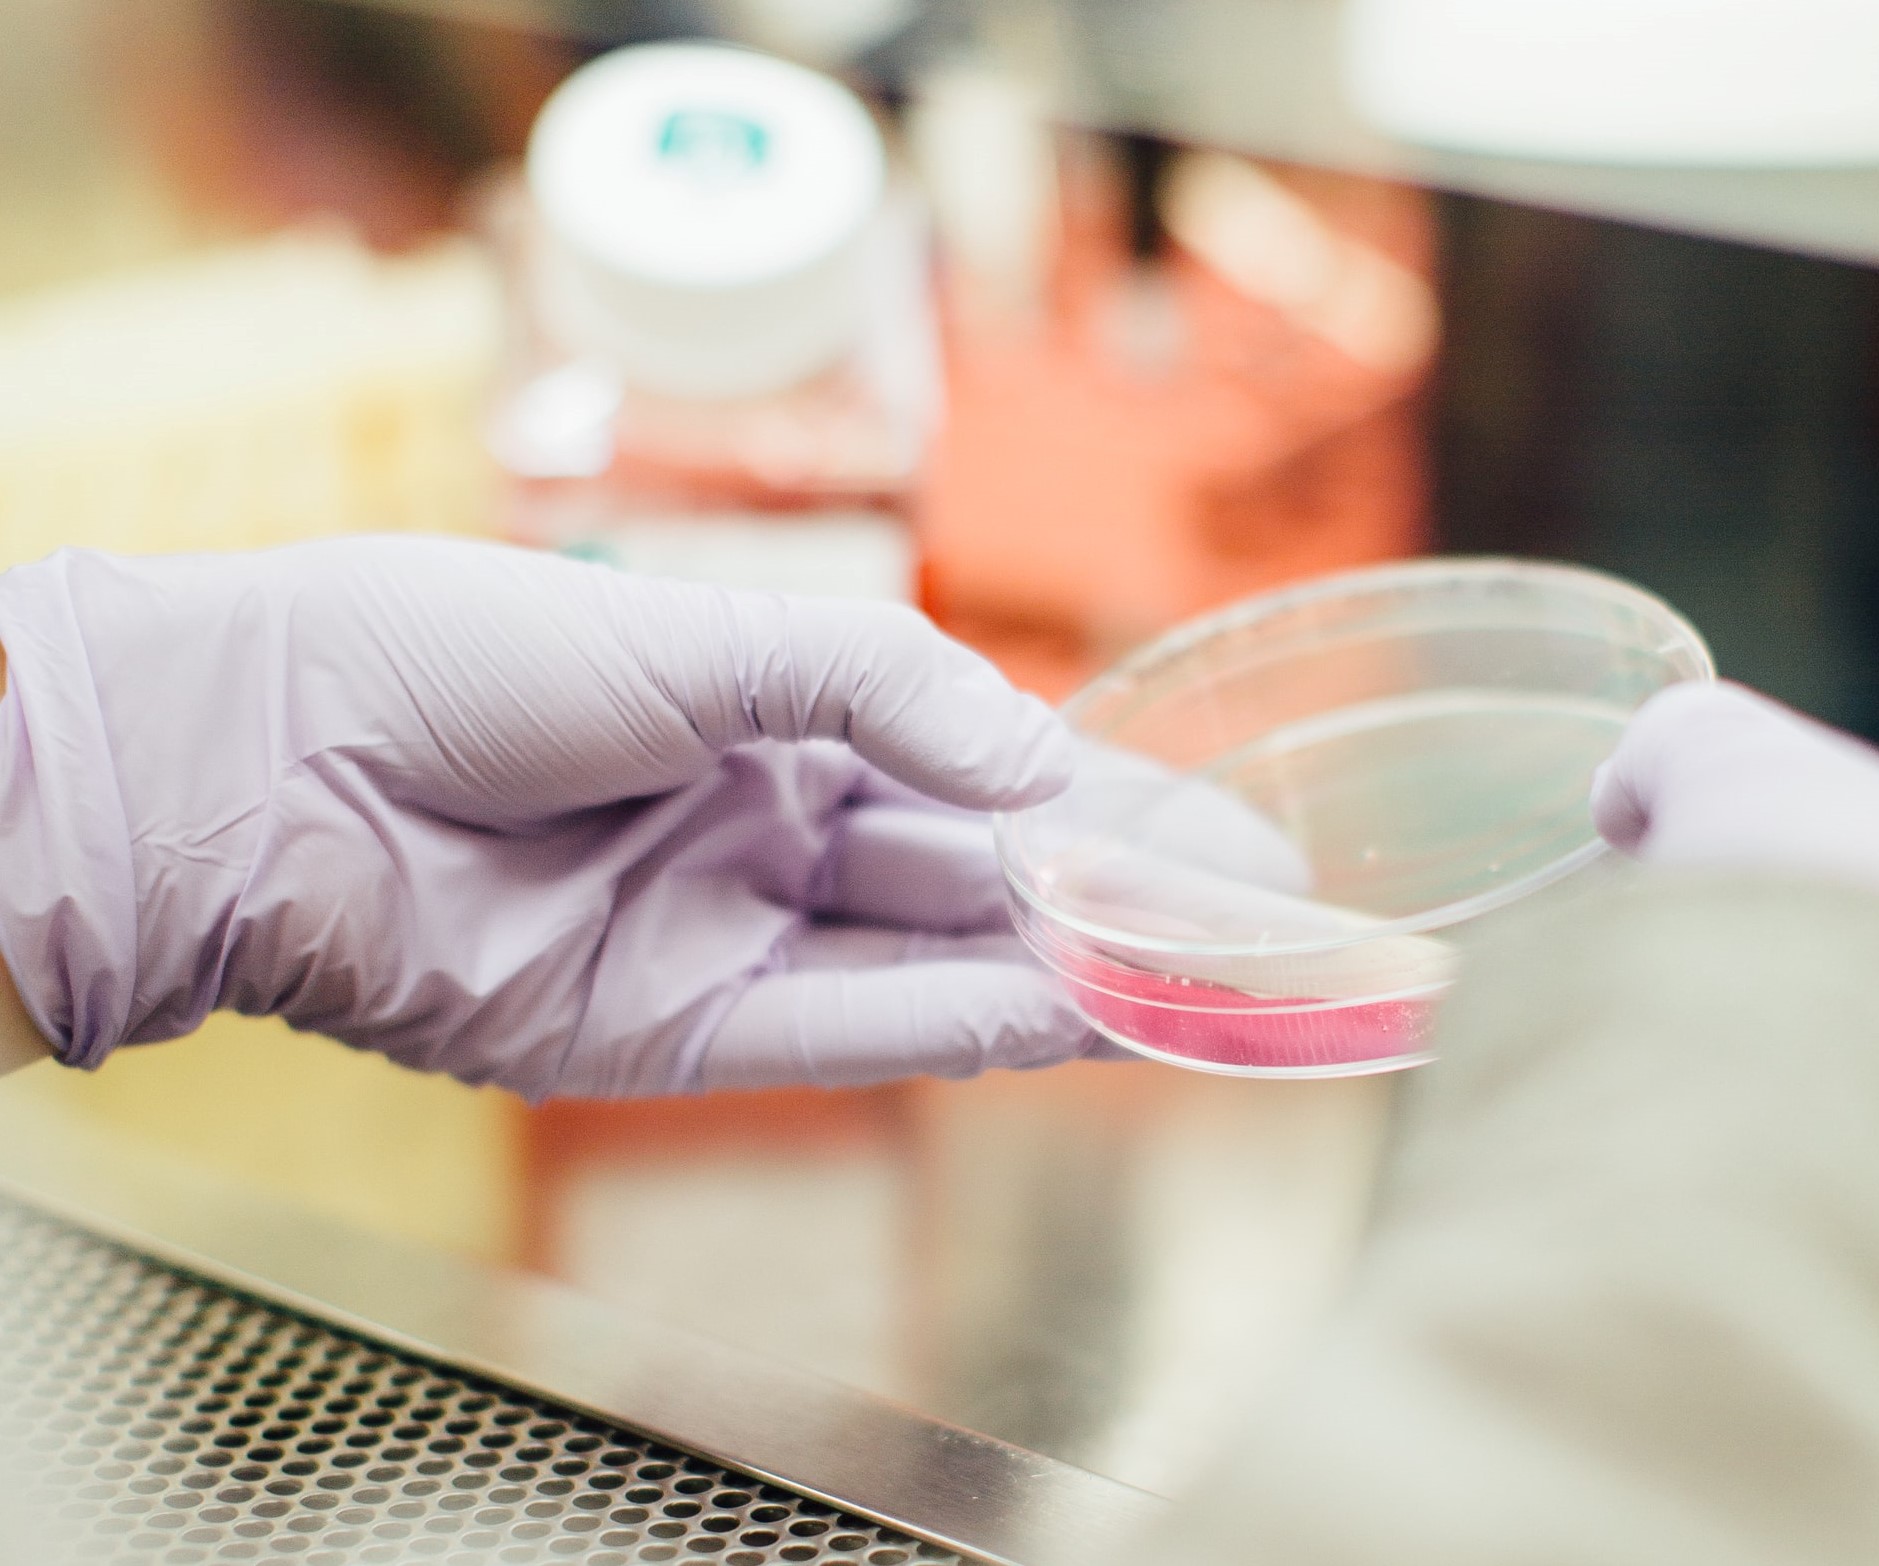

The study showed that both methods for administering FMT were lower in cost compared to standard treatment with antibiotics. FMT via naso-gastric tube was the least costly, with a mean cost of £8,877 per patient, while FMT via colonoscopy was £11,716 per patient. FMT via colonoscopy was also shown to be slightly more effective than treatment via naso-gastric tube, offering patients a higher quality of life. Two other standard antibiotic treatments vancomycin and fidaxomicin were compared in the model but both these treatments were shown to be more costly and less effective than either of the FMT interventions. Moreover, Vancomycin was the most expensive and the least effective treatment.
Professor Peter Hawkey, formerly of the University of Birmingham said, “We at the University of Birmingham pioneered this treatment as the UK’s first third party FMT service. FMT is not currently a widespread treatment for this disease but by showing that it not only saves lives, but is also significantly more cost effective, we hope that this could be one of the first steps towards the treatment being accepted more widely.”